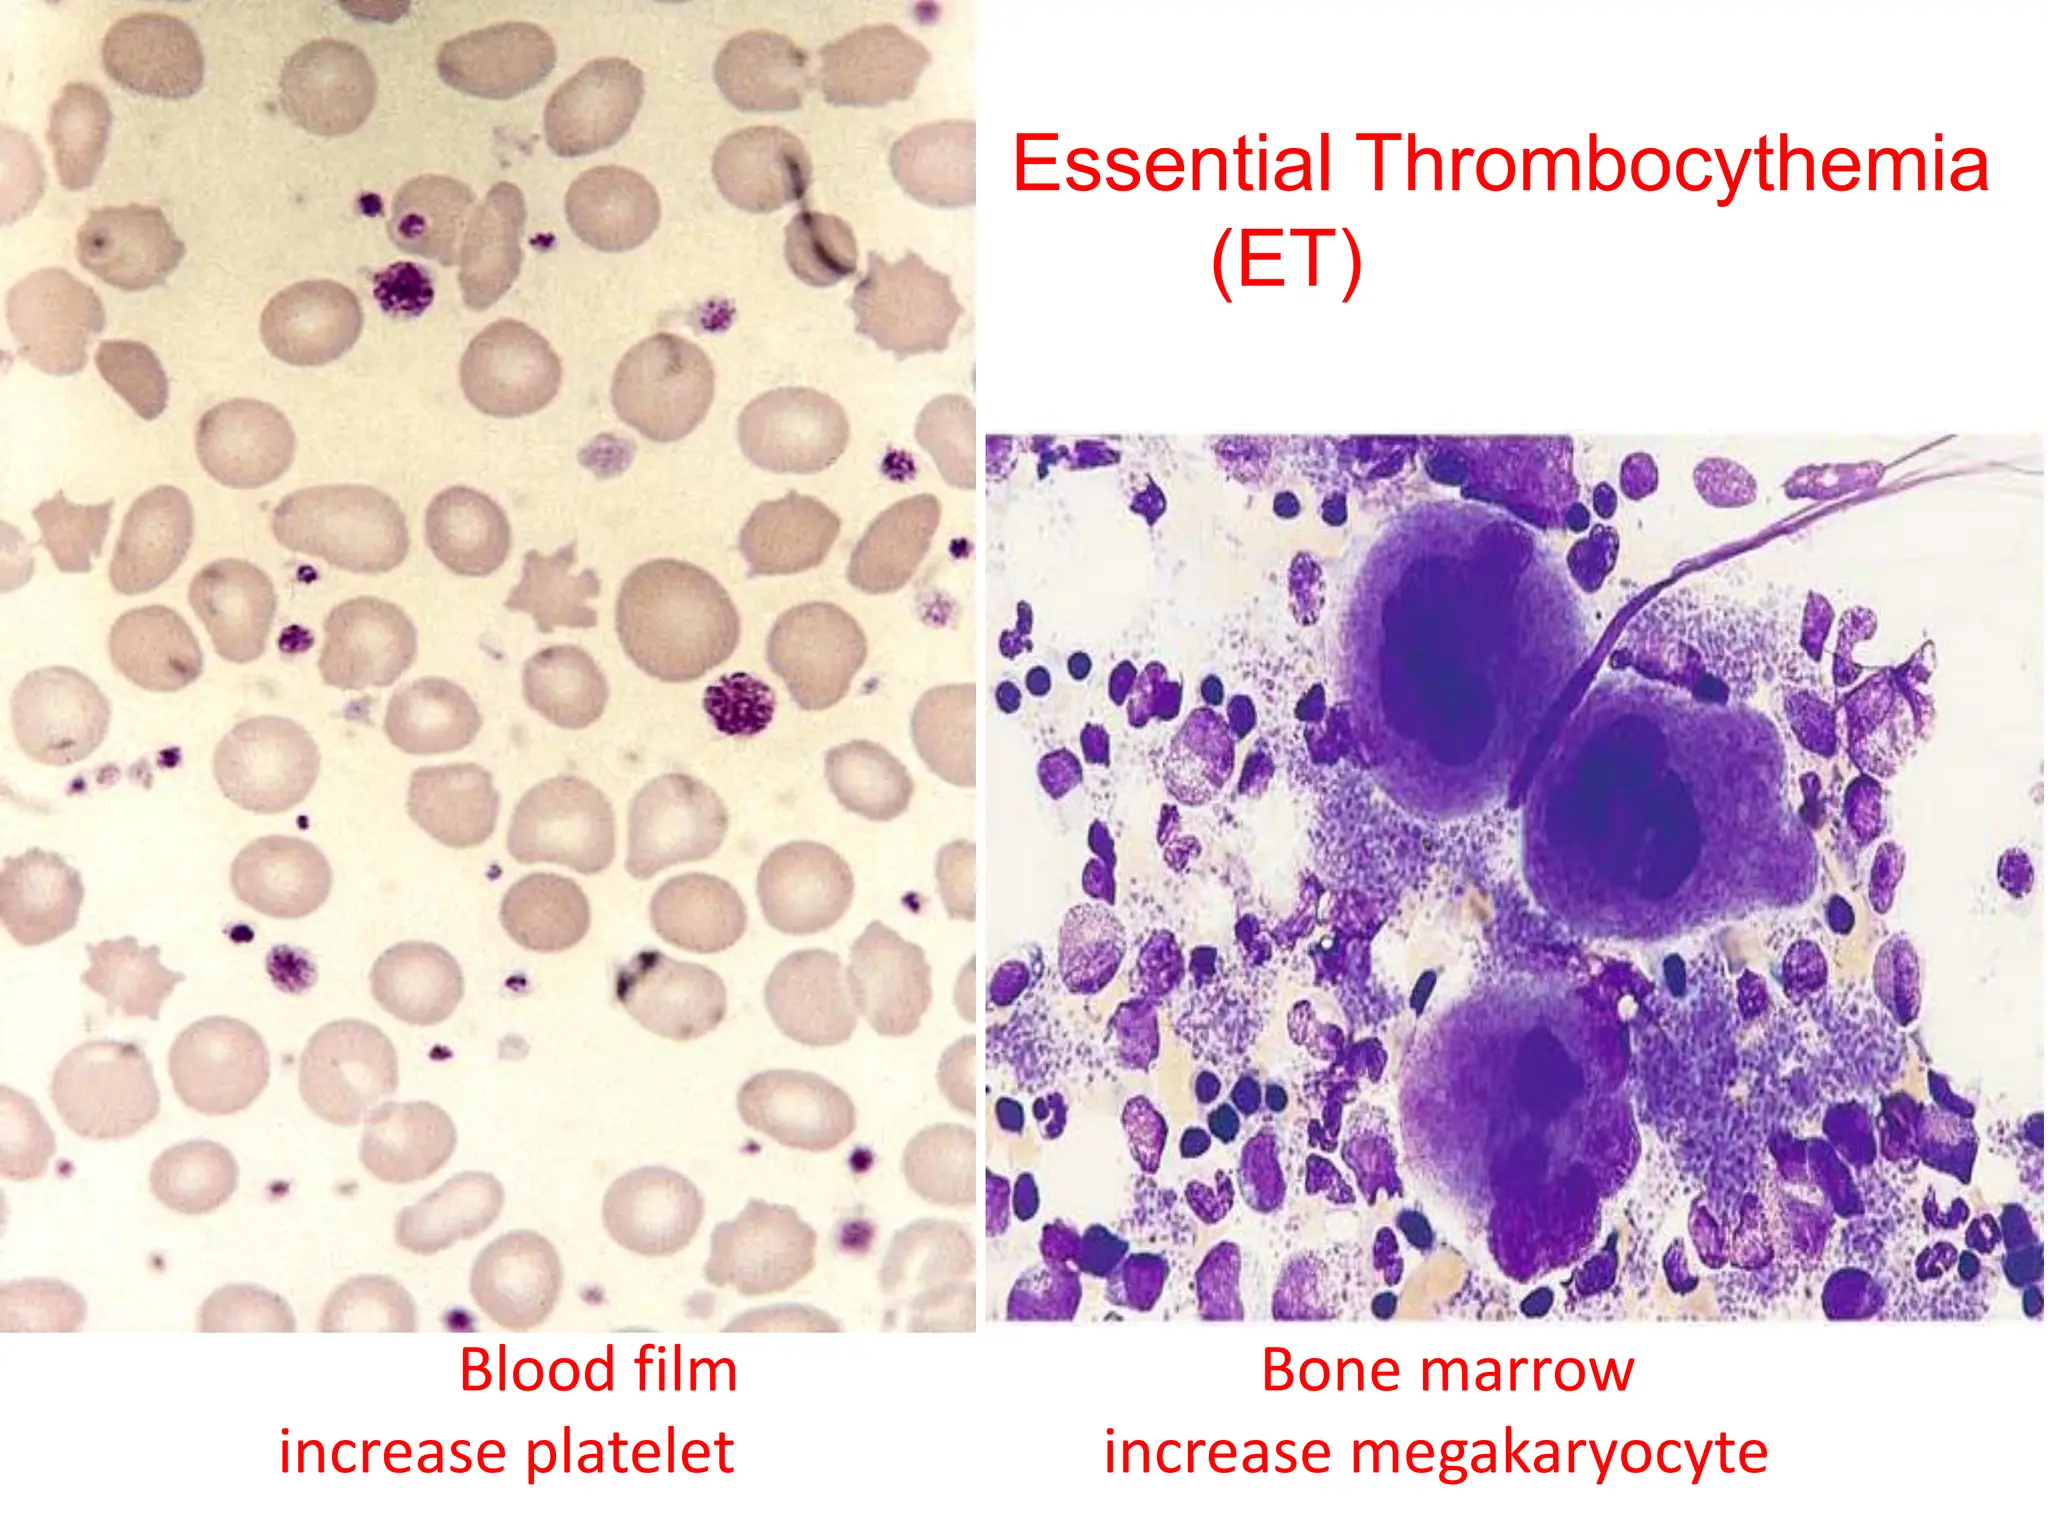
Blood film Bone marrow
increase platelet increase megakaryocyte
Essential Thrombocythemia
(ET)

Myeloproliferative neoplasms (MPNs) are clonal hematopoietic disorders resulting in the overproduction of myeloid lineages, including granulocytes, erythrocytes, and megakaryocytes, often associated with mutations such as JAK2. The document outlines various types of MPNs, specifically Polycythemia Vera (PV), Essential Thrombocythemia (ET), and Myelofibrosis (MF), their clinical features, diagnostic criteria, and potential treatment options. Chronic Myeloid Leukemia (CML) is also discussed, highlighting the presence of the Philadelphia chromosome as a significant marker for diagnosis.